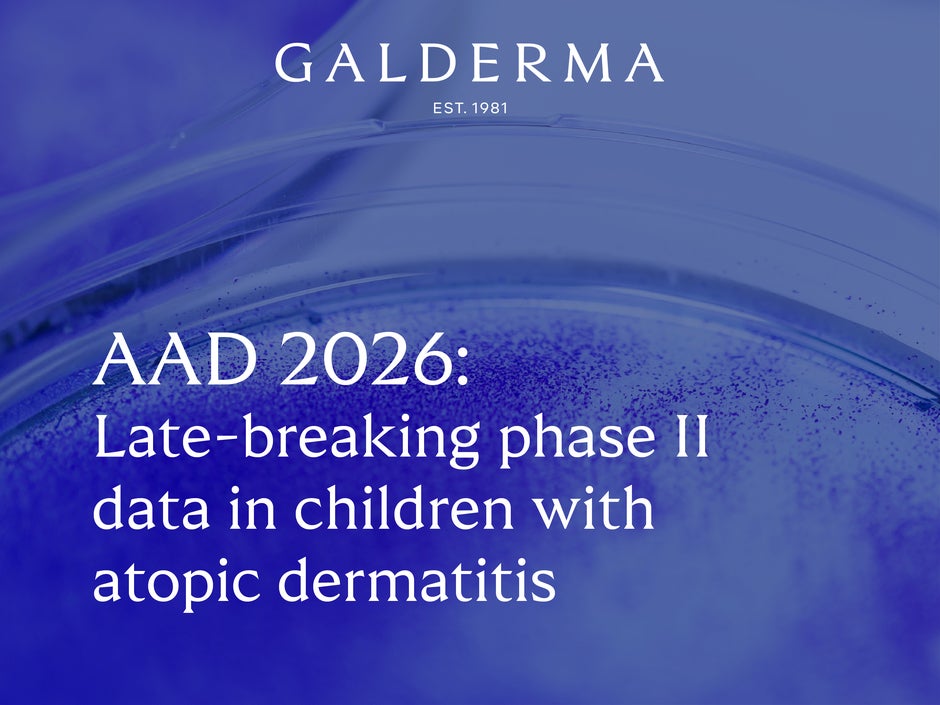
AAD 2026 LBA

AAD 2026: Late-breaking nemolizumab data demonstrate clinically meaningful benefits for children aged 2 to 11 with moderate-to-severe atopic dermatitis
- Pharmacokinetics, safety and efficacy clinical study data show that nemolizumab achieved clinically meaningful reductions in skin lesions and itch through Week 16, which were sustained up to a year in children aged 2 to 11 with moderate-to-severe atopic dermatitis1
- These findings reinforce the previously established safety and efficacy of nemolizumab in adults and adolescents with moderate-to-severe atopic dermatitis, for which it is approved by multiple global regulatory authorities2,3
- Up to 25% of children are affected by atopic dermatitis, and currently there are limited approved treatment options for children living with moderate-to-severe atopic dermatitis4,5
Zug, Switzerland – March 28, 2026 – Galderma (SIX: GALD) today announced new phase II data showing that nemolizumab was well tolerated and effective in children (aged 2 to 11 years) with moderate-to-severe atopic dermatitis, with a clinically meaningful and sustained reduction in skin lesions and itch for up to a year.1 Results will be presented in a late-breaking session at the 2026 American Academy of Dermatology (AAD) Annual Meeting.
Atopic dermatitis is the most common inflammatory skin disorder in children, yet treatment options in the moderate-to-severe pediatric setting are limited.5 The disease can have a significant impact on quality of life for both the patients and their loved ones, with persistent itch and recurrent skin lesions often disrupting sleep, school and relationships.5-8
“Atopic dermatitis can affect many aspects of children’s lives including
schoolwork, emotional development, and social confidence. This
burden also often extends to caregivers who can experience anxiety, stress, and sleep loss. In our study, nemolizumab demonstrated a clinically meaningful benefit in children with moderate-to-severe atopic dermatitis, helping to reduce skin lesions and itch up to one year, and had a similar safety profile as with adults and adolescents.”
LAWRENCE EICHENFIELD, M.D.
PROFESSOR OF DERMATOLOGY AND PEDIATRICS AT THE UNIVERSITY OF CALIFORNIA SAN DIEGO SCHOOL OF MEDICINE AND CHIEF OF PEDIATRIC DERMATOLOGY AT
RADY CHILDREN'S HOSPITAL SAN DIEGO, UNITED STATES
Clinically meaningful reductions in skin lesions and itch in children with atopic dermatitis
A phase II study (NCT04921345) was conducted to assess the pharmacokinetics, safety, and efficacy of nemolizumab in children (aged 2 to 11 years) with moderate-to-severe atopic dermatitis.1 Results showed that nemolizumab pediatric doses were associated with similar pharmacokinetic exposure compared to adults and adolescents, and were well tolerated and effective in children, with clinically meaningful reductions in skin lesions and itch through Week 16 and sustained up to Week 52.1 Amongst two of the cohorts evaluated, children aged 7 to 11 and 2 to 6, with nemolizumab doses of 5 mg (for weights ≥10 kg to <20 kg), 10 mg (for ≥20 kg to <30 kg), and 15 mg (for ≥30 kg):
- Investigator’s Global Assessment of skin lesion improvement to clear (0) or almost clear (1) skin was observed as early as Week 4, with 41-47% of patients achieving it by Week 161
- A 75% improvement in the Eczema Area and Severity Index score was observed as early as Week 4, with 69-73% of patients achieving it by Week 161
- Itch relief - defined as a score of ≥4 on the Peak Pruritus Numerical Rating Scale (PP-NRS) - was observed as early as Week 1, with 72% of children aged 2 to 6 and 59% of children aged 7 to 11 achieving it at Week 161
- Similar or higher response rates were observed at Week 52 for all these clinical endpoints demonstrating sustained efficacy over a year1
These phase II findings are consistent with the previously established safety and efficacy of nemolizumab in adults and adolescents with moderate-to-severe atopic dermatitis.2,3
“These new data in children below 12 years old build on nemolizumab’s robust and growing clinical evidence base in moderate-to-severe atopic dermatitis. They also demonstrate our commitment to advancing research to address key areas of unmet need in dermatology, such as atopic dermatitis in children, which has such a high prevalence and burden."
CHRISTOPHE PIKETTY, M.D., PH.D.
GLOBAL PROGRAM HEAD, THERAPEUTIC DERMATOLOGY
GALDERMA
For adult and adolescent patients with moderate-to-severe atopic dermatitis, nemolizumab is the first approved monoclonal antibody that specifically targets IL-31 receptor alpha, inhibiting the signaling of IL-31.2,3,9 IL-31 is a neuroimmune cytokine that drives itch and is involved in inflammation and skin barrier dysfunction in both atopic dermatitis and prurigo nodularis, and in fibrosis in prurigo nodularis.9-11 It is approved by multiple regulatory authorities around the world for the treatment of adults and adolescent patients with moderate-to-severe atopic dermatitis and adults with prurigo nodularis, including in the U.S. and European Union.2,3
For more information about the impact of atopic dermatitis on children and families, watch this video. Media can find more information and resources on atopic dermatitis in this toolkit.
About Galderma
Galderma (SIX: GALD) is the pure-play dermatology category leader, present in approximately 90 countries. We deliver an innovative, science-based portfolio of premium flagship brands and services that span the full spectrum of the fast-growing dermatology market through Injectable Aesthetics, Dermatological Skincare and Therapeutic Dermatology. Since our foundation in 1981, we have dedicated our focus and passion to the human body’s largest organ – the skin – meeting individual consumer and patient needs with superior outcomes in partnership with healthcare professionals. Because we understand that the skin we are in shapes our lives, we are advancing dermatology for every skin story. For more information: www.galderma.com.
For further information:
Christian Marcoux, M.Sc. Chief Communications Officer christian.marcoux@galderma.com +41 76 315 26 50 | Emil Ivanov Head of Strategy, Investor Relations, and ESG +41 21 642 78 12 |
Richard Harbinson Corporate Communications Director richard.harbinson@galderma.com +41 76 210 60 62 | Jessica Cohen Investor Relations and Strategy Director +41 21 642 76 43 |
Céline Buguet Franchises and R&D Communications Director +41 76 249 90 87 |
References
- Eichenfield LF, et al. Pharmacokinetics, safety, and efficacy of nemolizumab in children (aged 2 to 11 years) with moderate-to-severe atopic dermatitis. Late breaking abstract presented at 2026 American Academy of Dermatology (AAD) Annual Meeting; March 27-31, 2026; United States
- Nemluvio® U.S. Prescribing Information. Available online. Accessed March 2026
- Nemluvio® European Medicines Agency. Summary of Product Characteristics. Available online. Accessed March 2026
- Schoch JJ, et al. Atopic dermatitis: Update on skin-directed management: clinical report. Pediatrics. 2025; 155(6):e2025071812. doi:10.1542/peds.2025-071812
- Eichenfield LF, et al. Patient-reported impact of atopic dermatitis on pediatric and adolescent patients with moderate-to-severe disease: results of a real-world, cross-sectional survey. Pediatr Dermatology. 2025;42:523-531. doi:10.1111/pde.15940
- Vittrup I, et al. The association between atopic dermatitis, cognitive function and school performance in children and young adults. Br J Dermatol. 2023;188(3):341-349. doi: 10.1093/bjd/ljac058
- Mostafa N and Smith S D. Improving psychological health outcomes in children with atopic dermatitis. Clin Cosmet Investig Dermatol. 2023;16:2821-2827. doi: 10.2147/CCID.S393254
- Kelly K A, et al. Skin disease in children: Effects on quality of life, stigmatization, bullying, and suicide risk in pediatric acne, atopic dermatitis, and psoriasis patients. Children (Basel). 2021;8(11):1057. doi:10.3390/children8111057
- Silverberg JI, et al. Phase 2B randomized study of nemolizumab in adults with moderate-to-severe atopic dermatitis and severe pruritus. J Allergy Clin Immunol. 2020;145(1): 173-182. doi: 10.1016/j.jaci.2019.08.013
- Bewley A, et al. Prurigo nodularis: A review of IL-31RA blockade and other potential treatments. Dermatol Ther (Heidelb). 2022;12(9):2039–2048. doi: 10.1007/s13555- 022-00782-2
- Kwatra SG, Misery L, Clibborn C, Steinhoff M. Molecular and cellular mechanisms of itch and pain in atopic dermatitis and implications for novel therapeutics. Clin Transl Immunology. 2022;11(5):e1390. doi: 10.1002/cti2.1390